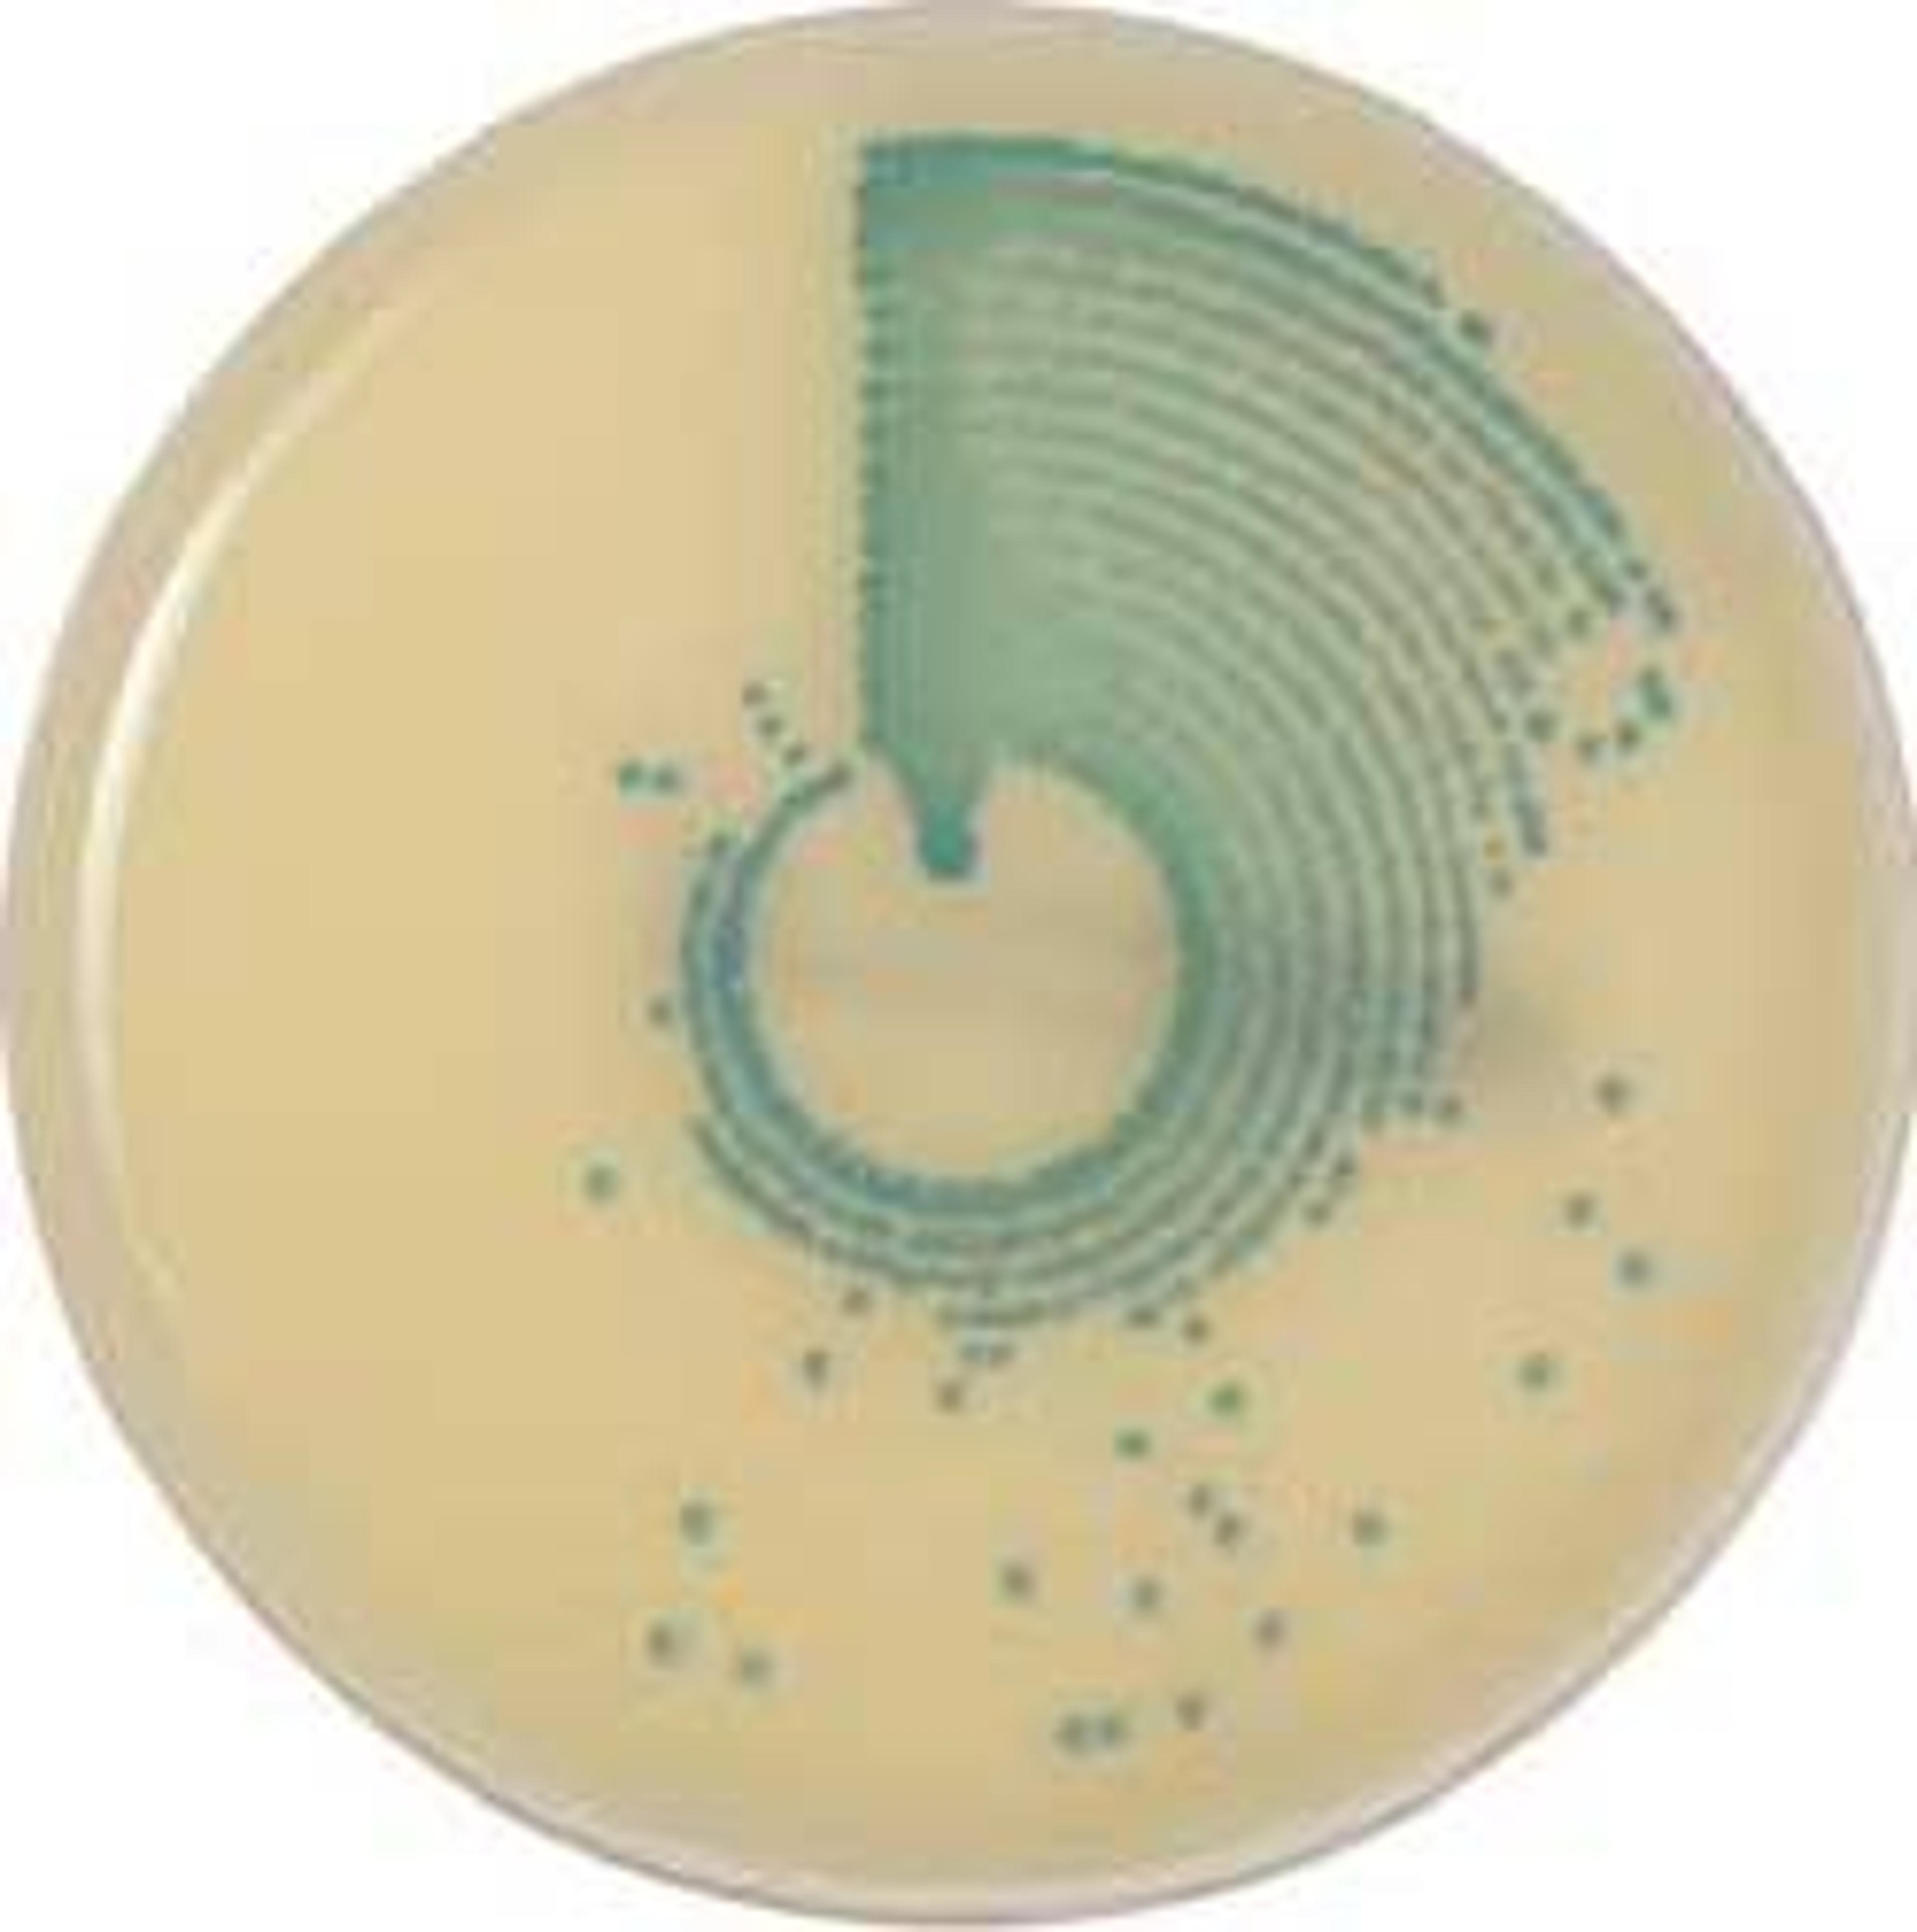

News & Articles
Selected Filters:
bioMérieux expands point-of-care diagnostics with SpinChip acquisition
This innovative technology aims to improve acute care outcomes, particularly for myocardial infarction diagnosis.
BIOFIRE FILMARRAY Tropical Fever Panel receives US FDA Special 510(k) clearance
Tropical Fever Panel a syndromic PCR test, targets the causes of tropical fever infections
bioMérieux receives CE marking for VIDAS VITAMIN B12 TOTAL
For use on all VIDAS immunoanalyzers, VIDAS VITAMIN B12 TOTAL is an automated quantitative blood test that measures total vitamin B12 concentration
Collaboration drives antimicrobial stewardship improvements
Understand the importance of fostering cross-department collaboration for an optimal antimicrobial stewardship program
bioMérieux receives US FDA 510(k) clearance for its AST System VITEK REVEAL
bioMérieux, announces that its VITEK REVEAL AST System, reporting results directly from positive blood cultures, has received US Food and Drug Administration (FDA) 510(k) clearance
bioMérieux receives CLIA-waiver approval for the BIOFIRE SPOTFIRE
The respiratory/sore throat (R/ST) panel receives Dual 510(k) clearance and CLIA-waiver approval
bioMérieux's BIOFIRE SPOTFIRE R Panel Mini receives FDA CLIA-waiver
Rapid and accurate multiplex PCR-based test brings critical results to the patient in just 15 minutes
bioMérieux announces CE-marking of VIDAS KUBE, the next generation system in the VIDAS immunoassay portfolio
The latest addition to this innovative range combines advanced technology with the recognized values of the VIDAS solution
bioMérieux announces the CE marking of VIDAS tests for Chikungunya virus diagnosis
Based on single-sample testing the VIDAS Anti-CHIKUNGUNYA IgM and IgG are easy to use and accessible to all laboratories
bioMérieux receives De Novo FDA Authorization for its BIOFIRE Joint Infection (JI) Panel
The BIOFIRE solution is a U.S. FDA-cleared and CE-marked closed multiplex PCR and fully automated system that integrates sample preparation, amplification, and detection
MYACUTECASE™: A free mobile application to support clinicians in decision-making and monitoring of patients
New mobile application will help clinicians choose the right biomarker tests to order for a particular patient and facilitate the interpretation of results
bioMérieux molecular tests efficiently detect SARS-CoV-2 Omicron variant
bioMérieux conducts in-depth analyses of its molecular tests on emerging variants of concern
bioMérieux launches EPISEQ SARS-COV-2, a cloud-based software application for the epidemiological surveillance of SARS-CoV-2 variants
EPISEQ SARS-COV-2 will support microbiology labs in identification and reporting from raw sequencing data related to SARS-CoV-2 variants
bioMérieux launches BIOFIRE MYCOPLASMA test for mycoplasma detection in biopharmaceutical products
Easy-to-use molecular biology test delivers results in less than one hour
bioMérieux Submits 510(k) Application to the FDA for BacT/ALERT® VIRTUO™ Next Generation Automated Blood Culture System
The new system demonstrates bioMérieux’s commitment to automated blood culture - a foundational step to infectious disease diagnosis